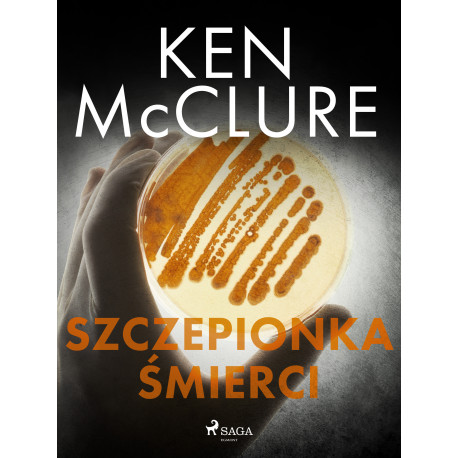

Ingen varer
Szczepionka śmierci
(Ebog, epub, Polsk)- Type: Ebog
- Format: epub
- Sprog: Polsk
- ISBN-13: 9788728438213
- Se flere detaljer ▼
Formater og udgaver
Beskrivelse
Czy trzeba bać się kolejnej pandemii i szczepić się przed nowym wariantem ,,hiszpanki", która w 1918 r. zabiła 40 mln. ludzi? Kiedy w laboratorium trwają prace nad szczepionką przeciwko grypie, znienacka wpada tam banda ,,ekologów", która bestialsko morduje jednego z zatrudnionych w nim naukowców. Dr Steven Dunbar próbuje ustalić przyczyny zabójstwa w tajnym instytucie i wyjaśnić, co tak naprawdę tam planowano. Gdy w jego otoczeniu giną kolejni ludzie, hipoteza o pracach nad rekonstrukcją szczepu ,,hiszpanki" staje się coraz bardziej prawdopodobna. ,,Szczepionka" to szósty z thrillerów o śledztwach dra Dunbara, można go uznać za oddzielną historię lub czytać bez zachowania kolejności serii. Jeśli lubisz mrożące krew w żyłach intrygi w thrillerach medycznych i pasjonuje cię tematyka broni biologicznej, ,,Szczepionka śmierci" na pewno trafi w twój gust czytelniczy.
Dr Dunbar - seria nagradzanych thrillerów z udziałem Stevena Dunbara, byłego lekarza i członka jednostek specjalnych Inspektoratu Sci-Med. Bohater powieści Kena McClure’a wykorzystuje swoją wiedzę medyczną do wykrywania wykroczeń i przestępstw z dziedziny szeroko pojętej medycyny (przedmiotem jego śledztw są m.in. błędy w sztuce lekarskiej, handel narządami ludzkimi, szczepionki skażone genetycznie). Cykl powieści o doktorze Dunbarze to trzymające w napięciu thrillery, z przerażająco wiarygodnymi dla naukowców przewidywaniami medycznymi.
Ken McClure, właśc. Kenneth J. Begg (ur. 1942 r. w Edynburgu) szkocki mikrobiolog, wybitny lekarz i naukowiec, uznawany obecnie za najlepszego brytyjskiego autora tłumaczonych na 25 języków thrillerów medycznych. Pisarz zadebiutował w 1985 r. powieścią Kryptonim ,,Kowadło", kolejne utwory przyniosły mu międzynarodową sławę - krytycy literatury chętnie nazywają go szkockim Michaelem Crichtonem i przyrównują do Robina Cooka, mistrza thrillerów medycznych.
Læsernes anmeldelser (0)
Alle detaljer
| Forlag | SAGA Egmont |
| Forfatter | Ken McClure |
| Type | Ebog |
| Format | epub |
| Sprog | Polsk |
| Udgivelsesdato | 07-09-2022 |
| Udgiver | SAGA Egmont |
| Serie | Steven Dunbar |
| Serienummer | 6 |
| Oversætter | Krzysztof Uliszewski |
| Sideantal | 215 Sider |
| Filtype | epub |
| Filversion | 3.0 |
| Filformat | Reflowable |
| Filstørrelse | 454 KB |
| Kopibeskyttelse | DigitalVandmaerkning |
| Datamining | Ikke tilladt |
| ISBN-13 / EAN-13 | 9788728438213 |